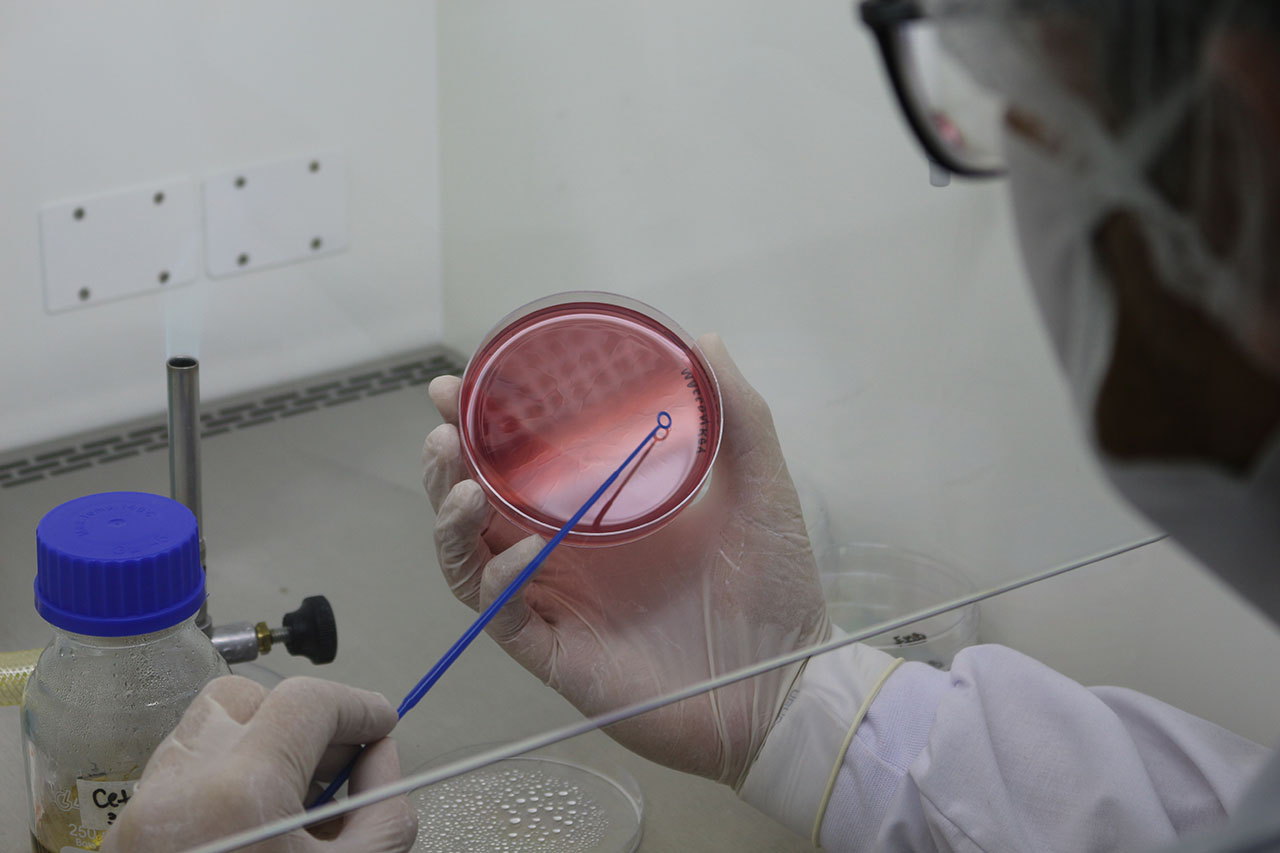

empresA
Sobre Nós

nossa história
A Piralabor Laboratório de análises é um laboratório especializado em analises de controle de qualidade físico-químico e microbiológico, que se especializa no desenvolvimento e aprimoramento de seus métodos para analises de água, cosméticos, Saneantes e produtos para a saúde podendo abranger a prestação de serviços para indústrias farmacêuticas e cosméticas, indústrias alimentícias, farmácias de manipulação e demais empresas que necessitem de análises de água, insumos, matérias primas, e produtos acabados.
MISSÃO
Oferecer serviços de análises laboratoriais com clareza e excelência que auxiliem empresas e indivíduos a identificar em seus produtos e serviços padrões de qualidade e ou fatores que ofereçam riscos à saúde da sociedade e meio ambiente, afim de atingir altos padrões aceitáveis de qualidade.
VISÃO
– Emissão de relatórios com resultados claros e confiáveis;
– Agilidade na comunicação e execução de todo o processo;
– Atualização dos métodos analíticos constantemente;
Valorizamos as relações entre colaboradores, clientes, fornecedores e meio ambiente, onde o ato de servir com excelência seja a base do nosso existir.
CULTURA ORGANIZACIONAL
Ética, Respeito, Comprometimento e Transparência.
SERVIÇOS
As análises e ensaios realizados pelo laboratório é utilizado como base compêndios oficiais brasileiros e internacionais como a farmacopeia Brasileira 5 e 6ed, Microbiological Examination of Nonsterile Products: Microbial Enumeration Tests and Tests for Especifird Microorganisms (USP40-NF35) e SMEWW 23ª edição 2017

ÁGUA
Água Purificada
Ensaios Físico-químicos
- pH;
- Condutividade;
- Cloro residual Livre.
Ensaios Microbiológicos
- Contagem de bactérias heterotróficas;
- Pesquisa de coliformes totais;
- Pesquisa de Escherichia coli;
- Pesquisa de Pseudomonas aeruginosa.
Água Potável
- Portaria Nº 888 de 4 de maio de 2021 (Básica)
- Portaria Nº 888 de 4 de maio de 2021 (Completa)
Ensaios Físico-químicos
- pH;
- Cloro residual Livre;
- Cor aparente;
- Características organolépticas.
- Turbidez
Águas Subterrâneas
- Conama nº 357 de 17 de março de 2005 (Completa)
- Conama nº 396, de 3 de abril de 2008 (Completa)
Padrões para lançamento de Efluentes
- RDC Nº 430 de 13 de maio de 2011 (Completa)
Águas Mineral e Água Natural, envasadas e Gelo
- RDC nº 274 de 22 de setembro de 2005 (Completa)
Características Microbiológicas para água Mineral e Natural
- RDC nº 275 de 22 de setembro de 20C

COSMÉTICOS e SANEANTES
Análises de Rotina
RDC Nº 907/24 e Farmacopéia brasileira 6ªed.
Ensaios Físico-químicos
- Determinação da viscosidade;
- Determinação de pH;
- Determinação de características organolépticas;
- Determinação da densidade Relativa.
Ensaios Microbiológicos
- Contagem de bactérias mesófilas;
- Contagem de bolores e leveduras;
- Pesquisa de Escherichia coli;
- Pesquisa de Pseudomonas aeruginosa;
- Pesquisa de Staphylococcus aureus;
- Pesquisa de Coliformes Totais e Termotolerantes
Análises para Registro
- Challenger Test – ISO 11930
- Time Kill
- Halo de Inibição
- Estabilidade Acelerada
- Estabilidade de Prateleira
Doseamento de teor de ativo
- Ácido Cítrico
- Ácido Acético
- Ácido Peracético
- Glutaraldeido
- Polyhexamethylene biguanide ( PHMB)
- Tensoativo catiônico
Atividade Enzimática
- Atividade enzimática Amilolítica
- Atividade enzimática Proteolítica
CERTIFICAÇÕES
CREDENCIAIS
Contamos com uma infraestrutura especializada e equipamentos calibrados semestralmente com certificação RBC.
Growth Promotion – Realizamos a promoção de crescimento em todos os nossos meios de cultura e caldos de diluição com cepas ATCC para garantir a confiabilidade do testes.

CONTATO
ENTRE EM CONTATO CONOSCO
ENDEREÇO
-
Estrada Municipal Fernando Luiz Landgraf (PNG 060), 370
Bairro: Cantareira - Pirassununga/SP
CEP 13634-760 - Caixa Postal: 95 - +55 11 99254-4478
- +55 19 3563-4368
- comercial@piralabor.com.br

EMPRESA
Piralabor Laboratório de Análises é um laboratório especializado em analises de controle de qualidade físico-químico e microbiológico que se especializa no desenvolvimento e aprimoramento de seus métodos para analises de água, cosméticos, Saneantes e produtos para a saúde.
Acesse nossas redes sociais
ENDEREÇO
-
Estrada Municipal Fernando Luiz Landgraf (PNG 060), 370 - Bairro: Cantareira
Pirassununga/SP - CEP 13634-760
Caixa Postal: 95 - 19 3563-4368
- 11 99254-4478
- comercial@piralabor.com.br